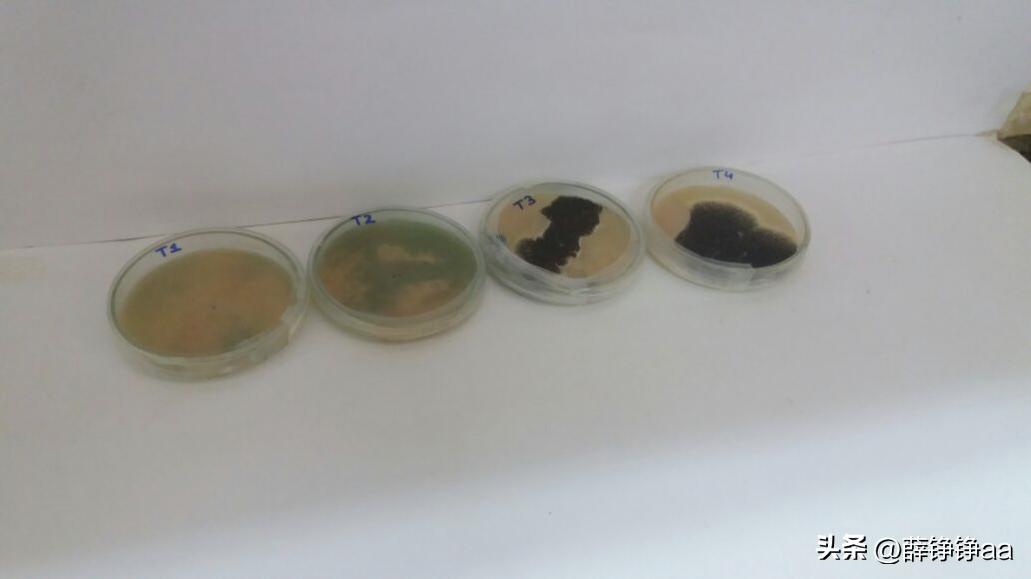
薄荷精油详细介绍,薄荷精油具有温和的能力
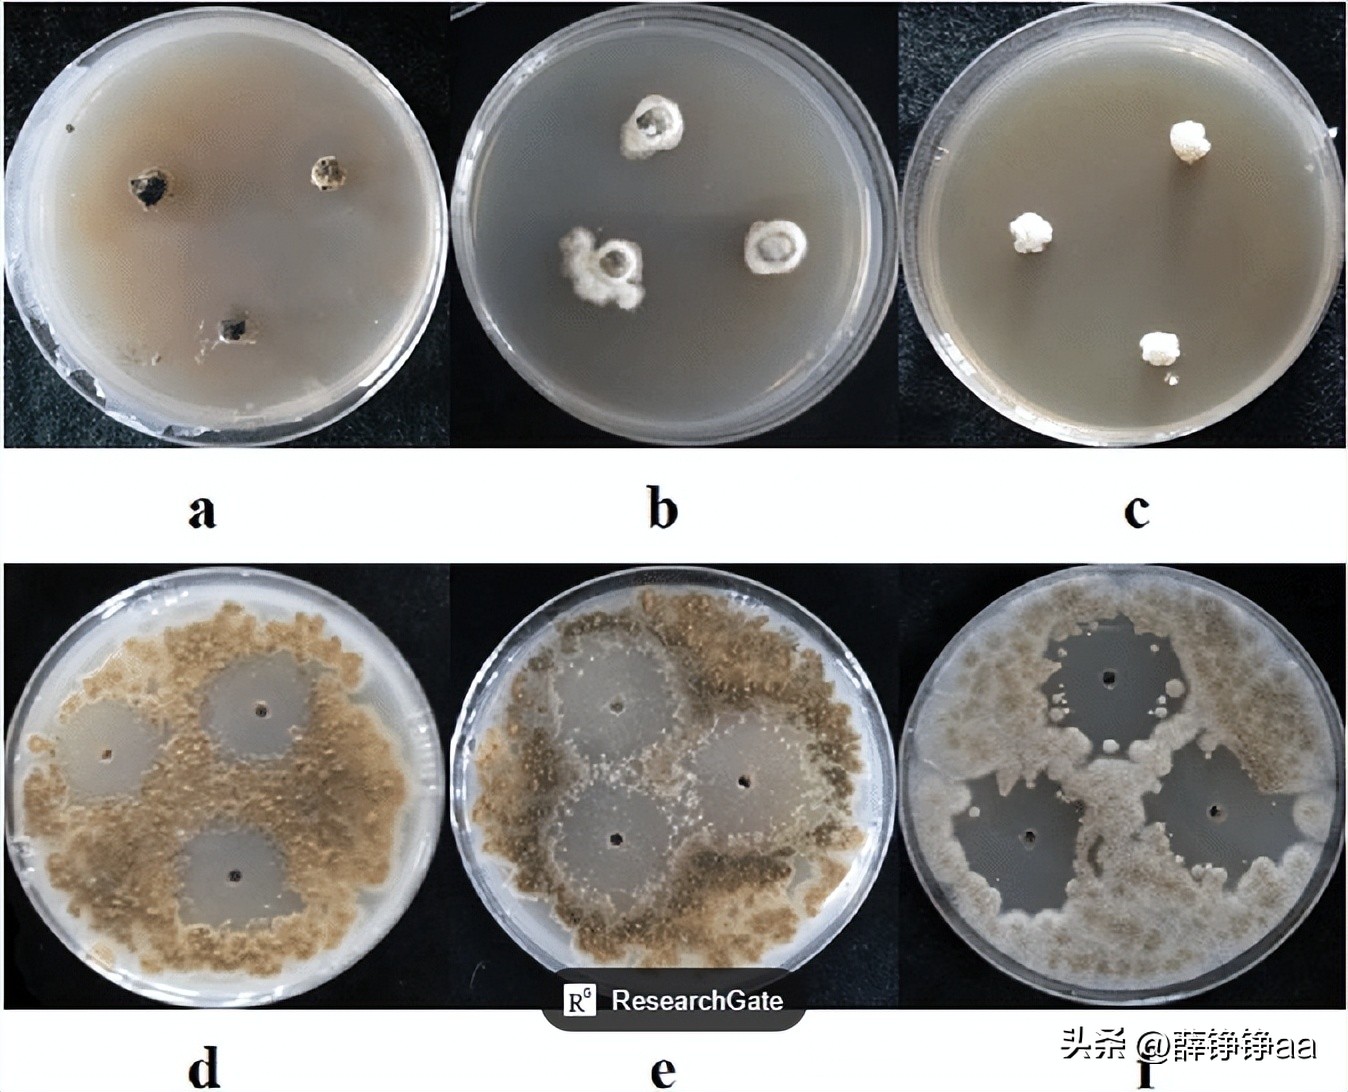
薄荷精油详细介绍,薄荷精油具有温和的能力

点击右上方关注,解锁每天好文章
文 | 薛铮铮aa
编辑 | 薛铮铮aa
引言
薄荷精油是一种常见的精油,具有许多独特的成分和抗菌效果。它的主要来源,是从薄荷植物中提取的,主要成分包括薄荷醇、薄荷酮和薄荷醛等。
薄荷醇是薄荷精油中的主要成分之一,具有强烈的清凉感,它不仅能够刺激皮肤的冷感受体,使人感到清爽和舒适,还具有 抗菌和抗炎 作用,可以有效地抑制细菌和真菌的生长,减少感染的风险。
薄荷属是这个植物科目中一个著名的属,在世界各地的温带地区广泛生长,特别是在欧洲、亚洲、非洲、澳大利亚和北美洲,薄荷属中的植物具有显著的生物活性,它在形态上具有广泛的变异性,并且其精油的化学成分非常多样。

薄荷精油的抗微生物活性
其中最为出名当的当属薄荷精油,它被广泛用于 呼吸系统疾病 的治疗,如支气管炎、鼻窦炎、结核病等,薄荷的化学成分复杂且极其多变,每个物种都有其特有的主要化合物,此外,精油的化学成分可能会根据生命周期阶段、植物器官、地理位置等因素而变化。
关于薄荷属的属性,目前根据研究,已报道了有几种,抗病毒、抗菌、抗真菌、高抗氧化性、细胞毒性、抗炎和抗过敏。
社会倾向于消除用于治疗不同生物病原体,而引起疾病的化学物质,全球消费者和食品安全机构已经引导研究人员,优先考虑使用天然替代品来控制这些疾病。

薄荷作为抗微生物剂,含有多种挥发性气味的精油,其复杂的成分组成富含具有抗菌、抗病毒和其他生物活性的分子,而在目前的食品产业中,真菌污染是一个普遍存在的问题,对水果和蔬菜的保鲜和贮存问题,造成了很大的困扰。
真菌的出现,可能会导致采后质量下降,损失产量,并且会增加经济成本,甚至有可能对人类健康造成威胁,控制真菌扩散以延长水果和蔬菜的供应链,对于确保食品安全和减少经济损失至关重要。
为了解决这个问题,研究人员将把此次研究的重心,放在探索 天然抗真菌剂 的潜力上面,以确定其对真菌的抗真菌作用,此次研究的目标之一,就是确定薄荷精油的化学成分,并评估四种重要的植物病原真菌和采后真菌,产生的抗真菌效果。

通过对薄荷精油的成分进行分析,研究人员发现其中存在多种具有抗菌、抗真菌和抗病毒活性的分子,这些活性成分可以对真菌生长和繁殖产生抑制作用,从而减轻真菌引起的食品污染问题。
为了评估薄荷精油的抗真菌潜力,涉及四种重要的植物病原真菌和采后真菌,研究人员利用不同浓度的薄荷精油,来测定其对这些真菌的抑制作用,结果显示,薄荷精油具有显著的抗真菌活性,进而可以有效地抑制这些真菌的生长和繁殖。
这些研究结果表明,利用薄荷精油作为天然抗真菌剂,可以延长水果和蔬菜的储存寿命,减少采后损失,并提供更安全的食品供应,这将对消费者的健康都带来重要的益处,但目前仍需要进一步研究,来确定薄荷精油在不同环境最佳应用条件。

薄荷精油的实验材料和方法
研究人员从实验田采集的植物材料中获得了M. spicata和M. suaveolens的精油,随后,将收集到的两种植物使用Clevenger型装置和3升蒸馏水进行 水蒸馏 ,蒸馏时间为3小时。
在使用无水硫酸钠进行干燥处理后,便可以将精油稀释到2%的二氯甲烷,并存放在玻璃瓶中,在无光的情况下以-18°C保存,直到进行气相色谱分析。

据分析,是在配备有毛细管柱的 Varian Saturn 2000 上进行的,并且使用相同的工作条件进行气相色谱和分裂模式注射,质谱范围在m/z 28-400内,电离电压为70 eV,随后需使用共色谱的标准烃类,计算线性保留指数,为接下来的研究做准备。
接下来的生物测定,需在Petri培养皿中进行,并且依赖于薄荷精油。研究人员在预先灭菌的土豆葡萄糖基烧瓶中,以200、300和400µg/mL的浓度溶解,温度保持在45-50°C,当培养基还是液态时,便可将其分配到Petri培养皿中。

为了测量两个垂直方向上的菌落直径来评估真菌的生长情况,Petri培养皿会接种在PDA培养基上,生长经过7天的菌落圆片,并且要在25°C的黑暗下孵育7天,在此之间,还需每天对每种精油、剂量和真菌,使用5个重复培养皿,进行3次。
而对照组的Petri培养皿中,只含有PDA/Tween 20和要分析的真菌,通过测量垂直菌落的直径来评估菌丝的生长情况。
真菌生长结果,经过方差分析进行了统计分析,随后使用HSD Tukey置信区间,来比较物种和处理,显著水平设置在P < 0.05,并且使用Statgraphics Centurion XVII软件分析数据。
商用精油的化学成分
研究人员根据 萜烯化合物 的类别,将留兰香、薄荷草和香罗勒的精油组成进行了分类:氧化单萜烯类化合物的含量为63.6%、92.0%和77.3%,碳氢化合物单萜烯类的含量为25.4%、4.0%和7.3%。倍半萜烯类化合物的含量分别为7.9%、3.1%和6.6%。
薄荷草中的主要化合物是薄荷醇及其衍生物,薄荷酮、醋酸薄荷酯、薄荷呋喃和新薄荷醇,而1,8-桉叶油醇的相对较高含量,薄荷草油又通常含有薄荷醇异构体及其酯类,以及薄荷酮等衍生物作为主要化合物。
研究中的一些样品展示了不同的化学组合,其中碳氢化合物单萜烯类化合物,或氧化单萜烯类化合物是主要成分。

留兰香中的主要成分,是香茴香酮和柠檬烯,还有一些显著含量的氧化单萜烯类化合物,但一些成分与其他氧化单萜烯类化合物不同,比如:1,8-桉叶油醇和二氢香茴香酮。
至于香罗勒,这里使用的精油,表现出该物种中两个最具代表性的均衡组合:薄荷酮氧化物和薄荷酮酮氧化物,以及少量的其他单萜烯类化合物,如柠檬烯或沙比醇。
M.suaveolens精油具有特征性的组合,以C3上富含含氧甲基薄荷醇骨架的化合物,为主要特征,如薄荷酮、薄荷酮酮,而类似香茴香酮和二氢香茴香酮的C2上,也富含氧化合物的化合物。

同时,研究人员也报道了其他的化学组合,如香茴醇和1,8-桉叶油醇型、富含芸香酮、以及对甲醇等单萜烯类的精油。
研究使香罗勒精油,获得了最佳的抗真菌活性结果,最高剂量为400 µg/mL,而在所有研究的真菌中,最大生长抑制率产生了100%。
虽然有个别真菌对于镰刀菌的抑制率只有94.21%,效果略有下降,但研究的结果仍然非常令人满意。
而当将剂量降低到200 µg/mL 时,香罗勒精油的 MGI 值会 显著降低 ,与更高剂量的结果相比,显示的MGI 百分比有较大差异,其中只有欧矮星灰霉病菌超过了50%,同时香薄荷和留兰香中的达尔夫常青藤病菌也表现出了类似的结果。
在Tukey HSD的事后检验中,显示了在测试条件下真菌生长结果的显著性,但欧矮星灰霉病菌,是对这三种薄荷精油处理敏感性最高的真菌。
通过使用香罗勒精油的治疗,研究人员发现,400 µg/mL 和300 µg/mL 剂量下的欧矮星灰霉病菌和镰刀菌,并没有什么显著差异,这恰恰说明该治疗是有效的,但对于达尔夫常青藤病菌的生长,两个剂量之间却存在着显著差异。

研究中得出关于薄荷精油对 四种致病真菌 的结果,与其他真菌物种的结果相似,研究还评估了薄荷精油对海岸孢霉菌的孢子萌发,和离体培养的菌丝生长,以及在木瓜果实上不同的浓度效果。
在对薄荷精油的抗真菌研究中,研究人员进行了一系列的测试,来评估其抑制真菌生长的效果,通过对孢子萌发和离体培养的菌丝生长进行观察,研究人员发现薄荷精油在这两个方面,都表现出强烈的抑制作用。
当研究人员在实验室离体环境中,添加了薄荷精油到培养基中时,他们观察到孢子的萌发率有着明显的降低,并且菌丝的生长速率也受到抑制,说明薄荷精油,可以有效地抑制真菌在离体环境中的生长。

随后,研究人员还进行了体内测试,来评估薄荷精油对真菌的 抑制效果 ,他们将薄荷精油,应用于感染了致病真菌的植物体内,并观察了病原菌在植物组织中的生长情况,结果显示,薄荷精油对这些真菌表现出了良好的抑制效果,可以有效地减轻病害的严重程度。
这些研究结果,都强调了薄荷精油作为抗真菌剂的潜力,它在孢子萌发和菌丝生长阶段,表现出良好的抑制作用,无论是在离体环境还是体内,它都能够有效地控制真菌的生长,特别是对于吉孔草黄酮病菌和其他致病真菌,以及薄荷精油的抑制效果尤其显著。
并且,这些发现有助于深入了解薄荷精油的抗真菌机制,并为其在农业和食品工业中的应用提供了科学依据,可以进一步探索薄荷精油的抗真菌成分,优化使用方法,并评估其与其他抗真菌剂的联合效果,以实现更广泛的应用。

紧接着,研究人员评估了B. *ucfk**eliana物种的菌丝生长、分生孢子产生和萌发情况,并将精油加入培养基,使用不同的测试精油,发现薄荷对其的效果最好。
而最近的研究结果表明,M. spicata可能是一种潜在的高效、安全的替代品,它可以作为控制贮存新鲜产品中B. cinerea的熏蒸剂,而它的主要成分是蒎烯酮,柠檬烯以及木瓜醇,研究人员当即就对腐病菌、立枯霉和晚疫病菌,进行了抗真菌活性测试。

挥发油对植物病原真菌,显示出明显的抗真菌活性,并且它使用的油浓度,比我们的浓度要高出一倍,不仅如此,挥发油还对柑橘黄单胞菌表现出显著的活性。
因此,M. suaveolens是目前已知最有效的精油,该油对黑曲霉显示出强烈的抗真菌活性。而M. suaveolens的生物活性已被广泛描述,其中最具代表性的,就是化合物薄荷酮氧化物。
它不仅可以用于抗真菌和抗氧化活性,由于其在使用中的低风险,还可以用作食品添加剂和调味剂。

结语
通过此项研究我们得知,薄荷醇和薄荷酮是留兰香中的主要化合物,薄荷脑和薄荷酮是M. piperita中的主要化合物,而薄荷酮氧化物和薄荷酮氧化物是M. suaveolens中的主要化合物。
榕属是所有经过测试的真菌中最敏感的,这三种精油虽然抑制了其生长,但同时也获得了最佳的抗真菌活性结果,最高剂量为400 µg/mL,在所有研究的真菌中产生100%的最大生长抑制,除了对镰刀菌的抑制率为94.21%。
薄荷精油具有多种成分,主要包括薄荷醇和薄荷腈等,这些成分赋予了其独特的香气和功效。它也被证实具有较强的抗菌效果,并可以用于口腔和皮肤的护理,因此,在正确使用的情况下,薄荷精油可以成为一种天然的抗菌选择,并提供美容与健康的功效。

